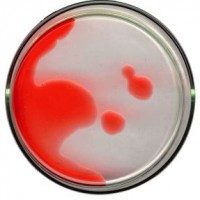
manfaat-tes-kadar-hemoglobin-pada-trimester-2

Seperti layaknya ketika menstruasi, wanita yang sedang hamil juga merasakan nyeri punggung yang jauh lebih menyakitkan ketimbang ketika mereka sedang haid. Nyeri di punggung ini biasanya terjadi ketika masa hamil tua dan sewaktu melahirkan. Akan tetapi ada juga nyeri punggung pada kehamilan trimester 2 , yang membuat ibu hamil menjadi sangat … [Read more...]